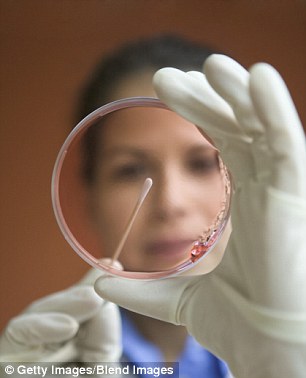

科技大佬痴迷长生不老术:投巨资研究死亡治愈

谷歌联合创始人塞奇-布林,希望有朝一日能够“治愈死亡”。现在,包括谷歌在内的美国科技巨头纷纷加入到抗衰老的研究并且不惜投入巨资

英国老年医学理论家奥布里-德五十度灰。德五十度灰认为第一个能够活到1000岁的人已经降生。在他看来,我们可以借助基因工程学手段改造我们的细胞以避免衰老过程,进而让寿命达到1000岁。他的观点并非空穴来风,因为科学家已经借助这种手段大幅提高蠕虫、苍蝇,甚至于老鼠的寿命

英国医学研究委员会前首席执行官科林-布莱克默。布莱克默坚信人类的寿命存在一个上限。他给出的上限是120岁,任何人的寿命都很难超过这一上限
据国外媒体报道,从古至今,人类一直梦想着能够永葆青春,长生不老,尤其是拥有巨大财富和权势的达官显贵。现在,科技大佬纷纷投入巨资研究“长生不老术”,俨然成为一种潮流。在这股潮流中,财大气粗的谷歌扮演了领导者角色。谷歌联合创始人塞奇-布林希望有朝一日能够“治愈死亡”。谷歌旗下风险投资机构 掌门人比尔-马里斯相信人可以活到500岁。俄罗斯亿万富翁和媒体大亨德米特里-伊茨科夫启动了所谓的“2045行动”研究项目,试图通过将大脑——连同大脑的意识——植入机器化身的方式实现永生。
达官显贵的梦想
古人相信这个世上存在神奇的长生不老药,能够实现人类最渴望做到的事情,那就是永生。在中国古代,很多皇帝都追求永生,将永生的希望寄托在玉石和黄金等贵重 物质身上。可怕的是,这些物质经常造成致命后果。16世纪,特兰西瓦尼亚女伯爵伊丽莎白-巴瑟将对抗死亡的努力做到极致,用少女的血沐浴,也因此被称之为 “吸血女伯爵”。此外,还有一位声名狼藉的科学家将含有狗精液、睾丸和血液的混合物注入自己体内。相比之下,他还是庆幸的,毕竟不是将所谓的长生不老药喝到肚里。牙买加人则不然,他们的长寿秘方是龟阴囊汤。
现在,延长寿命仍旧是很多达官显贵追求的梦想。谷歌风投掌门人比尔-马里斯便认为人类的寿命可以达到500岁。他说:“我们拥有一系列生命科学工具,能够做到你所能想到的任何事情。我只是希望能够活得足够长,不想早早离开人世。”
在科技产业,马里斯并不是唯一一个坚信科技进步能够在不久的将来大幅延长人类寿命的人。现在,美国的科技巨头投身抗衰老研究已经成为一种现象,财大气粗的谷 歌扮演了领导者角色。谷歌联合创始人塞奇-布林希望有朝一日能够“治愈死亡”。据悉,科技巨头们已投入数十亿美元,研究如何抗击衰老过程。他们的目标虽然 一致,但原因不尽相同,有的希望帮助人类,有的因为家人或好友去世带来的心理震撼,有的则因为对死亡的恐惧。此外,金钱也是一个重要促进因素。如果有人能 够研发出一项技术,让人类的寿命可以达到数百年之久,这项技术必将带来巨大财富,让他/她成为一个超级富有的人。
引发伦理问题
对于科技巨头们追求长生不老的做法,你可能报以嘲笑。他们认为自己能够解决衰老问题,就像解决一个运算问题一样。软件巨头拉里-埃里森“无法理解”人们为何 认为死亡不可避免,抱着这种想法的人似乎深陷中年危机而无法自拔。英国老年医学理论家奥布里-德五十度灰认为第一个能够活到1000岁的人已经降生。在他看 来,我们可以借助基因工程学手段改造我们的细胞以避免衰老过程,进而让寿命达到1000岁。他的观点并非空穴来风,因为科学家已经借助这种手段大幅提高蠕虫、苍蝇,甚至于老鼠的寿命。德五十度灰表示我们需要摒弃“衰老不可避免”的想法,应该将身体当成一辆老爷车,只要维护得当便可继续使用。
网络支付服务PayPal联 合创始人彼得-泰尔投入350万美元研究长寿技术。一些科学家认为这是一种疯狂的做法,是在浪费宝贵的研究经费。与其将这笔资金用于研究抗衰老,不如投向 其他更靠谱的研究。英国医学研究委员会前首席执行官科林-布莱克默坚信人类的寿命存在一个上限。他给出的上限是120岁,任何人的寿命都很难超过这一上限。
不过,世界上一些最优秀的科学家都致力于长寿研究。他们将目光投向一系列引人注目的技术,例如基因工程学改造,利用微型机器人处理出现问题的细胞,用机器或者克隆版器官取代人体器官。在当前的所有长生不老法中,最令人感到吃惊的莫过于将人类的意识“上传”给机器。
任何一种惊人或疯狂的长生不老法都不可避免地引发一系列伦理问题。这种研究需要投入多少资金?对永生的追求是否“掠夺”本用于日常病痛和重大疾病的研究经 费?寻找长生不老法对已经拥挤不堪的地球有何意义?如果机器人技术可让我们实现永生,此时的我们应该被称之为人类还是机器?一些亿万富翁不愿意看到自己的 精彩人生走向终结,其他人难道也抱着同样的想法吗?很多影片和著作都围绕可以永生的吸血鬼展开,但吸血鬼也时常抱怨永生给他们带来的孤独和乏味。

非洲裸鼹鼠。为了揭开人类衰老的谜团,一些科学家将目光投向长寿的裸鼹鼠,希望能够破解裸鼹鼠的基因秘密
加拿大亿万富翁彼得-尼加德坚信干细胞能够帮助我们实现长寿的梦想。他把自己的大部分财富都用于研究干细胞的用途,甚至在皮氏培养皿中培育自己的干细胞。干细胞能够发育成很多不同的人体组织,也就是说,它们可以作为人体的“备用零件”,修复受损的细胞或者器官
加拿大亿万富翁彼得-尼加德坚信干细胞能够帮助我们实现长寿的梦想。他把自己的大部分财富都用于研究干细胞的用途,甚至在皮氏培养皿中培育自己的干细胞。干细胞能够发育成很多不同的人体组织,也就是说,它们可以作为人体的“备用零件”,修复受损的细胞或者器官
盘点延寿技术
重写DNA
加利福尼亚生命公司是谷歌旗下的一家秘密延寿研究机构,招募的科学家包括辛西娅-凯尼恩。凯尼恩曾成功对蛔虫进行基因工程学改造,让它们的寿命达到普通蛔虫的10倍。研究中,她让蛔虫的daf-2基因部分瘫痪。有趣的是,活到100岁的人的daf-2基因更有可能发生变异。凯尼恩认为传说中的青春之泉并非一个不可实现的梦想,而是能够在将来的某一天成为现实。据信,谷歌的研究团队正在研发一种药物,能够模拟一种不仅能够限制人类的身高,同时还与长寿有关的基因。
在寻找长寿的秘诀时,科学家不仅将目光聚焦蛔虫,一种长相丑陋的动物也成为他们的优先研究对象。这种动物就是裸鼹鼠。科学家希望破解裸鼹鼠的基因秘密,进而 揭开人类衰老的谜团。裸鼹鼠没有毛发,长得一点也不可爱。不过,它们对癌症免疫,寿命超过30岁,是普通鼹鼠的10倍。专家们认为裸鼹鼠的长寿与它们在地 道内只能呼吸到少量氧气这一事实有关。呼吸到少量氧气意味着它们的新陈代谢速度很慢,大幅延缓细胞衰老速度,进而获得长寿。
微型机器人
根据谷歌工程总监雷-库兹韦尔的预测,到了21世纪30年代,我们会将数百万微型机器人——纳米机器人——送入体内,增强我们的免疫系统,从分子层面保持健 康的体魄。这种医学装置的尺寸仅相当于人体血细胞,可以以药丸的形式吞下,而后随着血液进入身体各处,运送激素和修补损伤。
纳米机器人的优势在于不会像化疗等疗法那样产生有害的副作用。副作用通常因药物进入体内后无法进行“精确打击”所致。相比之下,纳米机器人则能精确锁定特定 的细胞,甚至细胞的特定DNA片段。动物实验已经取得成功,纳米机器人成功治愈老鼠的糖尿病。10年前,库兹韦尔在一部著作中首次提到这种带有科幻色彩的 想法,当时遭到很多科学家的嘲笑。随着动物实验的成功,怀疑者最终闭上嘴巴。
干细胞
另一种对抗衰老的方式是利用干细胞。干细胞是人体的微观构件。加拿大亿万富翁彼得-尼加德坚信干细胞能够帮助我们实现长寿的梦想。他把自己的大部分财富都用 于研究干细胞的用途。干细胞能够发育成很多不同的人体组织,也就是说,它们可以作为人体的“备用零件”,修复受损的细胞或者器官。现在,科学家已成功从血 液、牙齿、骨髓和体脂肪中提取干细胞。
尼加德70多岁,是一个服装帝国的创始人。他在皮氏培养皿中培育自己的干细胞,而后将其注入体内,一年注射4次。尼加德认为干细胞不仅能够延长自己的寿命, 同时还能让自己变得更年轻。他在一段宣传视频中说:“干细胞能够颠覆游戏规则,能够消除所有疾病,甚至有可能让我们永生。”视频中,他将自己的开拓性研究 与达芬奇取得的成就相提并论。
一些科学家表示尼加德对逆转衰老过程的痴迷让干细胞研究背负恶名,因为他的这种做法与干细胞研究的真正目标“拯救生命”背道而驰。但纽约医生莱昂内尔-比森赞同尼加德的做法。他说:“如果你是一个非常富有的人但并没有保存自己的干细胞,那你就是一个十足的笨蛋。”
注入年轻血液
一些人认为用年轻血液替换衰老的血液能够延长寿命。教皇英诺森八世1492年去世,据说死前喝了3名男孩的血,试图吸收他们的元气。虽然这项输血室验最终以悲剧告终,但他的想法并不荒唐可笑。老鼠实验结果显示年轻老鼠的血浆能够修复老年老鼠的精神能力。
这种修复通过所谓的“异种共生”过程实现,听起来好似出自弗兰肯斯泰因博士的笔记。实验中,年老体弱的老鼠与年轻健康的老鼠的侧腹缝合在一起,让它们的血液供应合为一体。实验结果表明虽然老年老鼠变得更年轻更健康,但年轻老鼠却出现早衰。
目前,加利福尼亚州斯坦福大学正在进行一项人体实验,使用静脉滴注法将年轻人的血液注入老年痴呆症患者的体内,看看能否产生类似的效果。与老鼠相比,参与这 项实验的人无疑是幸运的,因为他们并没有像老鼠一样缝合在一起。项目负责人托尼-维斯-科莱表示如果实验取得成功,他们希望能够从年轻血液中提取到促成这 种结果的物质,而后将其转化成药物,治疗疾病。这项研究的目的是研发药物,但富豪们却看到了其他用途。科莱表示在老鼠实验结果公布之后,很多身体健康的富 豪纷纷与他联系,询问这种方法能否延长他们的寿命。
克隆和机器器官
一些科学家认为我们可以利用克隆器官或者机器器官替换损伤的人体器官,进而实现长寿的梦想。石黑一雄的反乌托邦小说《别让我走》为我们描绘了这样一个可怕的 未来:一群年轻人逐渐发现自己居然是富人们的克隆,他们的健康器官不过是主人的“备用零件”,需要的时候便将他们杀死,取下“备用零件”而后给主人安上。 实际上,替换损伤器官无需这么残忍血腥。
科学家已成功利用3D打印机打印出活肾脏和活肝脏。打印过程中,人体器官细胞样本与水凝胶混合在一起。水凝胶是水和富含营养的物质的混合物。即使一个人已经 濒于死亡,也可通过所谓的“冷盐复活”过程为他移植器官。在此过程中,患者的血液被冰冷的盐水取代,用于降低体温,让患者进入假死状态。在此之后,医生便 可实施器官移植手术。
半人半机器
俄罗斯亿万富翁和媒体大亨德米特里-伊茨科夫投资数百万美元展开一项研究,被称之为“2045行动”,试图通过将大脑——连同大脑的意识——植入机器化身的 方式实现永生。这个机器化身是另一个自我,一个身体更为先进的自我。伊茨科夫表示他有无数兴趣爱好,希望“2045行动”能够让他拥有万年“不死之身”, 永远陶醉在自己的兴趣爱好中。
谷歌未来学家库兹韦尔相信永生并非不可能。根据他的预测,到了2045年,电脑的智商将超越人类,人类可以通过与技术融合超越生物学限制,将自己的意识上传 给电脑。他已经下定决心,一定要让自己活到2045年,那时的他将97岁高龄,成为他认为的人类进化新纪元“奇点”的受益者。库兹韦尔所说的“奇点”是指 电脑智能与人脑智能的融合。为了实现这个夙愿,他正对身体的生物化学进行“再编程”,每天摄入150种膳食补充剂,从维生素D到辅酶Q10。Q10在将糖变成细胞所需能量过程中扮演重要角色。

发表你的评论吧返回顶部
!评论内容需包含中文
